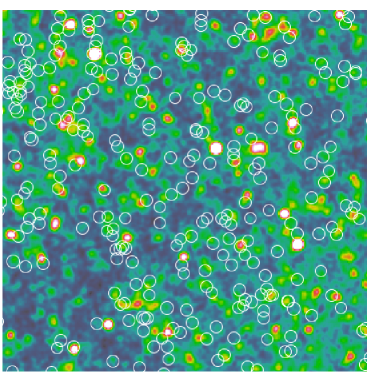
Refer to caption

HerMES: The Contribution to the Cosmic Infrared Background from Galaxies Selected by Mass and Redshift†
Abstract
We quantify the fraction of the cosmic infrared background (CIB) that originates from galaxies identified in the UV/optical/near-infrared by stacking 81,250 () K-selected sources () split according to their rest-frame vs. colors into 72,216 star-forming and 9,034 quiescent galaxies, on maps from Spitzer/MIPS (24m), Herschel/PACS (100, 160m), Herschel/SPIRE (250, 350, 500m), and AzTEC (1100m). The fraction of the CIB resolved by our catalog is ()% at 24m, ()% at 70m, ()% at 100m, ()% at 160m, ()% at 250m, ()% at 350m, ()% at 500m, and ()% at 1100m. Of that total, about 95% originates from star-forming galaxies, while the remaining 5% is from apparently quiescent galaxies. The CIB at m appears to be sourced predominantly from galaxies at , while at m the bulk originates from . Galaxies with stellar masses log(–11 are responsible for the majority of the CIB, with those in the log(–10 bin contributing mostly at m, and those in the log(–11 bin dominating at m. The contribution from galaxies in the log(–9.5 (lowest) and log(–12.0 (highest) stellar-mass bins contribute the least—both of order 5%—although the highest stellar-mass bin is a significant contributor to the luminosity density at . The luminosities of the galaxies responsible for the CIB shifts from combinations of “normal” and luminous infrared galaxies (LIRGs) at m, to LIRGs at m, to finally LIRGs and ultra-luminous infrared galaxies (ULIRGs) at m. Stacking analyses were performed using simstack, a novel algorithm designed to account for possible biases in the stacked flux density due to clustering. It is made available to the public at www.astro.caltech.edu/~viero/viero_homepage/toolbox.html.
Subject headings:
cosmology: observations, submillimeter: galaxies – infrared: galaxies – galaxies: evolution – large-scale structure of universe1. Introduction
The cosmic infrared background (CIB), discovered in Far Infrared Absolute Spectrophotometer (FIRAS) data from the Cosmic Background Explorer (COBE; Puget et al., 1996; Fixsen et al., 1998), originates from thermal re-radiation of UV/optical starlight (and to a lesser extent active galactic nuclei, or AGN, emission) absorbed by dust grains. The total intensity of this background is roughly equal to that of the combined extragalactic UV, optical, and near-infrared backgrounds (the “cosmic optical background”, or COB) indicating that, of all the light ever emitted by stars, about half has been absorbed and re-emitted by dust (Hauser & Dwek, 2001). While it is thought that the majority of the CIB originates from dusty star-forming galaxies (DSFGs; e.g., Le Floc’h et al., 2005; Lagache et al., 2005; Viero et al., 2009), how they relate to the sources that make up the COB, and what fraction of the CIB is resolvable as optical sources, is still unclear.
To definitively answer that question, ideally the CIB would be resolved into individual sources and matched to optical counterparts, but from the first DSFGs imaged in the submm (e.g., Smail et al., 1997; Barger et al., 1998; Hughes et al., 1998) it became quickly evident that identifying optical counterparts is a non-trivial exercise. The angular resolution afforded by single-dish submillimeter observatories results in beams containing multiple sources, such that in deep observations the spatial variation of the sky intensity eventually reaches the so-called “confusion limit” (e.g., Nguyen et al., 2010). This situation is made worse by the strong evolution undergone by DSFGs between the present day and (e.g., Pascale et al., 2009), such that only the brightest of DSFGs (equivalent to of the CIB; Oliver et al., 2010b) at 250m is resolvable into point sources. This is illustrated in Figure 1, where a cutout of the SPIRE 250m map is overlaid with positions of star-forming galaxies with masses between , at –1.5. The map is smoothed and color-stretched to highlight the regions of emission. It is clear that very few of the sources are detected individually—the rest lie almost exclusively on ridges of faint emission.
Given ancillary data of sufficient quality, this limitation can be overcome by stacking. Conceptually, stacking is very simple: imagine cutting out hundreds of thumbnails from a map centered on the positions where galaxies are known to be, and averaging those thumbnails together until an image of the average galaxy emerges from the noise. These positional priors can come in many forms, e.g., they could be catalogs of UV, optical, IR or radio sources. Note that the output is the average of that population in the stacked maps, i.e., there will likely be sources whose actual fluxes are higher or lower. Thus, the more homogeneous the sources comprising the input list, the more meaningful the stacked flux will be.
Stacking has been successfully applied to infrared maps by numerous groups looking to resolve the CIB with resolved sources. Frequently, Multi-band Imaging Photometer for Spitzer (MIPS; Rieke et al., 2004) 24m sources were used as positional priors because bright 24m sources are usually correlated with far-infrared (FIR) and submillimeter emission, and because of the large fraction of sources that are resolved in 24m maps (; Papovich et al., 2004). For example, Dole et al. (2006) showed that much of the CIB at 70 and 160m is resolved by sources whose flux densities at 24m are . Similarly, by stacking on maps from the Balloon-borne Large-Aperture Submillimeter Telescope (BLAST; Pascale et al., 2008), Devlin et al. (2009) and Marsden et al. (2009) demonstrated that close to the full intensity of the CIB at 250, 350, and 500m is resolved by 24m sources, and that roughly half of the CIB at 500m originates at . Jauzac et al. (2011) estimated the contribution to the CIB brightness at 70 and 160m from 24m sources by stacking in narrow redshift bins spanning . Berta et al. (2011), using PACS, and Béthermin et al. (2012c), using SPIRE maps, reconstructed number counts to flux densities below the confusion limit by stacking with 24m priors, and found that the integral of their counts resolved 58–74%, and 55–73% of the CIB at their respective wavelengths. And Penner et al. (2011) stacked 24m sources in AzTEC (1.1 mm) and MAMBO (1.2 mm) data, finding much of the resolved background at those wavelengths originates from .
Stacking has been used to address other questions as well. Pascale et al. (2009), stacking 24m sources on BLAST maps, measured the evolution of the infrared luminosity density with redshift, finding a significant rise in the temperatures and luminosities of sources with increasing redshift. Oliver et al. (2010a) used Spitzer “bandmerged” catalogs to measure the mass-dependency of specific star formation rates (sSFR)—the star-formation rate of the galaxy divided by its mass—over the redshift range . Viero et al. (2012) stacked high-redshift massive galaxies from the GOODS-NICMOS Survey (GNS; Conselice et al., 2011) on maps from PACS at 70–160m (Poglitsch et al., 2010), 870m from LABOCA (Weiß et al., 2009), and BLAST, finding that the bulk of the star formation occurs in disk-like galaxies, with a hint that spheroid-like galaxies harbor a low level of star formation as well. Similarly, Hilton et al. (2012) stacked a stellar-mass selected sample of galaxies drawn from the GNS on SPIRE maps and found evidence for an increasing fraction of dust-obscured star formation with stellar mass. And Heinis et al. (2012) stacked ultraviolet selected galaxies at on SPIRE maps, finding that the mean infrared luminosity is correlated to the slope of the UV continuum, .
While conceptually simple, in practice proper stacking is subtle and not without controversy. For sources that are uncorrelated (i.e., not clustered around other galaxies) the technique returns an unbiased estimate of the average flux density (e.g., Marsden et al., 2009; Viero et al., 2012). But if sources are clustered—which they inevitably will be—then a bias at some level will be present and must be accounted for.
Many solutions have been proposed to address this problem: some, like Béthermin et al. (2012c) correct for boosting with simulations. Alternatively, Béthermin et al. (2012c) and Heinis et al. (2012) fit the measured correlation function to the excess width of the measured stacked beam to estimate a correction. And Bourne et al. (2011) use a median statistic to perform their stacking, which is shown to be resistant to biases induced by outliers.
Still another method, developed independently by Kurczynski & Gawiser (2010), Roseboom et al. (2010), and Bourne et al. (2012), fits for the flux densities of multiple (correlated) lists simultaneously, thereby accounting for correlations as a part of the stack. The advantage of this technique is that it makes few assumptions and naturally takes into account the possibility that the potential clustering bias may be redshift and luminosity dependent. Here we build upon this technique to simultaneously measure the mean flux densities of galaxies selected by mass and divided into mass and redshift bins.
Our goal is to gain a better understanding of the contribution to the CIB from galaxies identified in the optical and near-infrared. In § 2 we present the data, and in § 3.1 we present our method, demonstrating its effectiveness with simulations in § 3.3. We ultimately use it to determine the total contribution to the CIB from K-selected galaxies (§ 4.3), and its dependence on redshift (§ 4.4), mass and color (§ 4.5), and luminosity (§ 4.6). The dependence of sSFR on these variables will be explored in a forthcoming paper (Arumugam et al. in prep.).
2. Data
We perform our analysis on the UKIRT Infrared Deep Sky Survey (UKIDSS; Lawrence et al., 2007), Ultra-Deep Survey (UDS) field, centered at coordinates . The UDS is the deepest survey undertaken by UKIDSS, covering in , , and to nominal 5 depths of 26.9, 25.9, 24.9 mag [AB]. Catalogs are based on optical and near-infrared (NIR) data in this field, while the maps on which the stacking analyses are performed span the mid-infrared to submillimeter. Here we briefly describe the catalog and maps.
2.1. Optical/Near-Infrared Catalog

Galaxy positions and redshifts come from a catalog based on the UKIDSS Ultra-Deep Survey (UDS; Lawrence et al., 2007; Warren et al., 2007) Data Release 8 and supplementary data (Williams et al. 2013, in prep.). Source detection, photometry, and spectral energy distribution (SED) fitting are described in detail by Williams et al. (2009), with recent updates to the catalog discussed by Quadri et al. (2012). A brief summary of the data follows: sources are detected in the UDS K-band mosaic using Source Extractor v2.5.0 (Bertin & Arnouts, 1996), and fluxes measured in other bands from PSF-matched images: from archival CFHT data, from the Subaru-XMM Deep Survey (SXDS; Furusawa et al., 2008), from the UDS DR8, and Spizter/IRAC imaging at 3.6, 4.5, 5.8, and 8m in the UDS field. An inspection of the number counts suggests that our catalog is essentially complete to for non-stellar objects, although it is difficult to rule out the possibility that there are a small number of diffuse and extended sources that do not make it into our sample. The de-blending technique of Labbé et al. (2006) and Wuyts et al. (2007) is used to extract matched IRAC fluxes. Objects near bad pixels in the optical or near-infrared images, or those with no optical coverage, are excluded, as well as stars, saturated sources, severe blends, or those near the edge of the image. These quality checks reduce the catalog from 171,392 to 81,250 objects, and the resulting effective image area is .
Photometric redshifts and rest-frame colors are derived by fitting the multi-band photometry with EAZY (Brammer et al., 2008). Stellar masses are obtained with FAST (Kriek et al., 2009) using a Chabrier (2003) IMF, solar metallicity, and Bruzual & Charlot (2003) stellar population models.
Quiescent and star-forming galaxies are classified based on the observed bimodality in a rest-frame color-color vs. (hereafter UVJ; Williams et al., 2009); this technique robustly separates red, dusty starbursts from red, dust-free, old stellar populations (see also Labbé et al., 2005; Wuyts et al., 2007). In addition to the quality checks listed above, sources whose best-fit SED has a high —which may be the result of poor photometry, artifacts in the images, or of a strong active galactic nucleus (AGN) component that is not a part of the EAZY template library— are excluded from the parent sample. Approximately 2,700 sources () exceed this limit; we explore the effect that inclusion of this subsample has on the total resolved CIB in § 5.3.
Our sample is selected at , where the catalog is essentially 100% complete. We calculate the corresponding mass completeness values in a manner similar to Quadri et al. (2012). Briefly, we scale the fluxes and masses of galaxies at slightly brighter magnitudes down to , and estimate the completeness as a function of mass and redshift as the fraction of objects below that mass at that redshift. Completeness estimates are plotted in Figure 2.
| Band | |||
|---|---|---|---|
| (m) | (arcsec) | (arcsec) | (steradians) |
| 24 | 6.0 | 6.3 | |
| 70 | 18.0 | 19.3 | |
| 100 | 7.4 | 7.0 | |
| 160 | 11.3 | 11.2 | |
| 250 | 18.1 | 17.6 | |
| 350 | 25.2 | 23.9 | |
| 500 | 36.6 | 35.2 | |
| 1100 | 30.0 | 30.0 |
2.2. Spitzer/MIPS
We use publicly available Spitzer/MIPS maps at 70, and 160m from the Spitzer Wide-Area Infrared Extragalactic (SWIRE) survey (Lonsdale et al., 2003) in the XMM Large-Scale Structure field (xmm-lss; Surace, 2005); and at 24m from the Spitzer UDS survey (SpUDS; PI: J. Dunlop), DR2. Maps have RMS levels of 0.5 mJy, 1.8 mJy and 19.9 Jy, respectively. We note that the absolute calibration uncertainties are 4, 7, and 12% at 24, 70, and 160m, respectively (Engelbracht et al., 2007; Gordon et al., 2007; Stansberry et al., 2007).
Following Béthermin et al. (2010), calibration corrections of 1.0509, 1.10, and 0.98, and aperture corrections of 1.19, 1.21, and 1.20, are applied at 24, 70, and 160m. Maps are in native units of (surface brightness), and are converted to for this analysis by dividing the maps by the solid angles of the measured instrumental point response functions111http://irsa.ipac.caltech.edu/data/SPITZER/docs/mips/ (PRFs), where , and is the peak value.
Also measured from the PRF is the effective full width at half maximum (FWHM) of the best-fit Gaussian, which can differ from nominal by as much as . This is done by simply finding the 2D Gaussian which provides the minimum value when differenced with the PRF, within a radius of (chosen as the approximate minimum of the primary lobe). Effective area and FWHM for each band are listed in Table 1.
2.3. Herschel/HerMES
We use submillimeter maps at 100, 160, 250, 350, and 500m from the the Herschel Multi-tiered Extragalactic Survey (HerMES; Oliver et al., 2012). HerMES is a guaranteed time (GT) key project, and consists of maps of many of the well studied extragalactic fields, which are divided into tiers of depth and area, observed with both the Spectral and Photometric Imaging REceiver (SPIRE Griffin et al., 2010) and the Photodetector Array Camera and Spectrometer (PACS Poglitsch et al., 2010). The UDS is a level 4 field, consisting of 20 repeat observations, and will be made available via HeDaM222http://hedam.oamp.fr/HerMES/ (Roehlly et al., 2011), as part of DR2.
2.3.1 Herschel/PACS
Data at 100 and 160m are taken with the PACS instrument and are processed with the Herschel Data Processing System (HIPE v10.2747; Ott, 2010). Maps were made with UniHIPE333herschel.asdc.asi.it/index.php?page=unimap.html in combination with Unimap444w3.uniroma1.it/unimap (Traficante et al., 2011; Piazzo, 2013). Maps are made using the default parameters, with the exception of the image pixel sizes, which we set to 2 and 3 arcsec at 100 and 160m, respectively. The advantage of this mapmaker over the standard one available through HIPE is that it does not require strong high-pass filtering or masking of bright sources (e.g., Wieprecht et al., 2009) to produce reliable maps, thus avoiding the attenuation of the fainter population as was found in (e.g., Lutz et al., 2011; Viero et al., 2012). The r.m.s. depths of the maps are 0.44 and 1.5 mJy at 100 and 160m, respectively.
2.3.2 Herschel/SPIRE
Data at 250, 350, and 500m are observed with the SPIRE instrument to a depth of 11.2, 9.3, 13.4 mJy (5), not including confusion noise, which from Nguyen et al. (2010) is 24.0, 27.5, and 30.5 mJy (5) at 250, 350 and 500m, respectively. Absolute calibration is detailed in Swinyard et al. (2010), with calibration uncertainties of . Maps are made with 3 arcsec pixels using SMAP (Levenson et al., 2010; Viero et al., 2013b).
2.4. AzTEC
We use maps at 1100m observed with the AzTEC camera (Wilson et al., 2008; Glenn et al., 1998) mounted on ASTE (Ezawa et al., 2004, 2008). The FWHM of the AzTEC beam on ASTE is 30 arcsec at 1100m, and the field of view of the array is roughly circular with a diameter of 8 arcmin. Calibration errors are quoted for individual observations to be 6–13% (Wilson et al., 2008; Austermann et al., 2010), depending on the source; here we adopt a value of 10%. The area covered is smaller than at the other bands, totaling after cropping the noisy outer edge. These data will be presented by Ikarashi et al. (in prep.).
2.5. Color Corrections
We apply color corrections to convert from the standard calibration to the actual measured SED of the stacked sources. As the part of the spectrum observed depends on the source’s redshift, the color correction is applied after first finding the best-fit SED in each bin. Consequently, each color correction is unique, though the difference in any one band across the full redshift range is never greater than . The color corrections per band, from lowest to highest redshift, are: 0.99–1.02 (24m); 0.97–1.02 (70m); 0.93–1.02 (100m); 0.99–1.00 (160m); 0.98–0.99 (250m); 0.99–1.00 (350m); 0.99–1.07 (500m); and 0.96–0.99 (1100m).
3. Method for Unbiased Stacking
As was shown by Marsden et al. (2009), stacking is formally the covariance between a catalog (or multiple catalogs) of positions , containing sources in pixel , and a map, . The mean of is , which represents the average number of sources in catalog per pixel. In the limit that sources are Poisson distributed on the scale of the beam, then the covariance is simply the mean of the map at positions , so that the average flux density of a given catalog is
| (1) |
where is the total number of pixels in the map.
If the catalog (or catalogs) in question is correlated on the scale of the beam, can simply be replaced with the variance, . What this does not account for—as pointed out by e.g., Chary & Pope (2010), Serjeant et al. (2010), and Kurczynski & Gawiser (2010)—is the possibility that some other, fainter, and potentially numerous sources (or the sources in companion catalogs), may be correlated with the sources in that catalog, and that neglecting them could introduce a bias.
We now present an algorithm, whose formalism is similar to those of Kurczynski & Gawiser (2010) and Roseboom et al. (2010), with the difference that only samples which could potentially be correlated (i.e., those in the same redshift range) are simultaneously fit. In the following section we provide the formalism, while step-by-step instructions are given in § 3.2.
3.1. Stacking Formalism
The following is a generalization of the formalism presented in Marsden et al. (2009), and is applicable to any catalog, including those that are clustered at angular scales comparable to that of the beam. For a map, , with pixels , and a set of lists, :
| (2) |
where the form the complete set of all objects in the Universe.
Note that, unlike in Marsden et al. (2009), we need not assume that be a Poisson-distributed number. Furthermore, separate lists can also be correlated, so that the covariances between them need not be non-zero. However, we still require that the instrumental noise is well behaved, i.e., , so that terms in vanish in the sum.
The amplitudes and in Equation 3.1 that satisfy can be quantified by writing their covariances with the map itself:
| (3) |
which can be re-written in matrix form by defining amplitude and covariance vectors:
| (4) |
and
| (5) |
From the covariances and the matrix which we label A, S is then simply
| (6) |
Notice the resemblance that the linear system in Equation 3.1 bears to that of a least-squares fit
| (7) |
whose residual is given by
| (8) |
In order to minimize this residual, we impose the following set of conditions:
These can be expressed in matrix form as
| (10) |
3.2. Method in Practice
Here we present the simultaneous stacking algorithm (simstack) used in this analysis, which we also make publicly available through an IDL code555www.astro.caltech.edu/~viero/viero_homepage/toolbox.html. The simultaneous stack is performed on one map at a time, and one group at a time, where groups are defined as catalogs which could potentially be correlated. For example, we group all lists in the same redshift range together (for a total of 8 groups), as we expect galaxies of different masses but equal redshifts to be correlated with each other. In other words, we assume that galaxies in different redshift slices are uncorrelated, and can be dealt with independently. Then, regardless of the code used, the method can be broken into four simple steps:
- Prepare
-
lists of RA and Dec by group, e.g., we divide each group (redshift slice) into 8 lists of mass and UVJ color; thus .
- Construct
-
layers, or “hits” maps, one for each list, where each pixel in the hits map contains the integer number of sources which falls into it.
- Convolve
-
the layers with an effective point spread function (PSF; we use a Gaussian) whose FWHM is equal to that of the the effective instrumental beam of the real map666If using the actual PRF of the instrument, take care that the orientation is correct, and if the field has been viewed at multiple angles, that the effective PRF is used..
- Regress
-
the convolved layers with the real map of the sky, ideally weighted by the noise777As dictated by the formalism of § 3.1, take care that the mean of the pixels to be fit in each layer equals zero..
Stacking should be performed on maps in . Errors can be estimated with a bootstrap technique, as described in § 3.4. Systematic errors in the method include beam area and calibration uncertainties. Note that calibration errors may be correlated between bands of the same instrument—an effect that should be accounted for when fitting models to stacked flux densities.
3.3. Testing the Method



Monte Carlo simulations consisting of 10,000 iterations are performed to test the estimator for biases. Two sets of simulated maps—one containing Poisson distributed (random) sources and the other of realistically correlated (clustered) sources—are constructed. Each map is a superposition of sources of varying mass, with the number of sources in each mass bin the same as that of real data. The flux densities given to the sources are drawn from Gaussian distributions centered on the flux densities of the measured mean stacked flux densities, and the width of the Gaussian five times that of the uncertainty on the stacked values, in order to introduce a significant level of stochasticity.
Sources in clustered simulated maps have their positions drawn from the actual positions of the catalog sources, in order to properly reproduce higher order correlations. Each map is then convolved with a Gaussian kernal approximating the instrumental beams, with FWHM values ranging from 5 to 35 arcsec.
We then perform stacking analyses on the maps in two ways: 1) with a traditional (e.g., Marsden et al., 2009) estimator; and 2) with the simstack algorithm. Finally, the stacked flux densities are compared to the known input mean values. The histogram in Figure 3 illustrates how the traditional estimator returns an unbiased estimate of the mean flux () of an unclustered simulation, but with an uncertainty that depends on the beam size (see also Viero et al., 2012). Similarly, Figure 4 shows the bias vs. source density (in number of sources per square arcmin) for clustered simulated maps, where the traditional estimator is represented by crosses and our simultaneous stacking method by circles. The data points are offset vertically for visual clarity. The traditional stacking estimator is relatively faithful for beams of , but quickly becomes biased, especially in catalogs with many sources. The simultaneous stacking instead returns an unbiased estimate of the mean flux density, with errors –3%, increasing with increasing beam size.
3.4. Estimating Uncertainties
In addition to measurement errors, we must account for potential systematic errors introduced by photometric redshifts. To address this potential bias we developed an extension of the typical bootstrap technique, hereafter referred to as the extended bootstrap technique, or EBT. Like a typical bootstrap, the EBT assembles new bins for stacking from the sources in the parent catalog, with the difference that rather than simply drawing sources randomly from the original bin, all of the sources in the catalog are first perturbed according to their redshift uncertainties, and then new bins are assembled from the new redshifts and masses. Simulated redshifts are determined by drawing randomly from the redshift probability distribution output by the photometric redshift code, EASY. Simulated masses, which change depending on redshift of the source, must be estimated as well. However, as estimating a new mass for every new redshift for every source would be overly labor intensive—particularly considering that most perturbations from the nominal redshift are rather small—we instead use the fact that the mass is a strong function of K-band magnitude with some slight additional dependence on color, and we estimate the new mass using the perturbed redshift and the observed magnitude and color. Finally, each simulated catalog is split up into bins resembling those of the original stack and new stacked flux densities are estimated with simstack. This is done 1,000 times. Measurement and bootstrap errors are then added in quadrature, though we note that the error budget is dominated by the EBT estimates.
The EBT accounts for the possibility of cross-contamination of galaxies across redshift and mass bins, in addition to the stochasticity of the catalog members measured by the traditional bootstrap technique, thus resulting in a more realistic error. We find that the EBT increases uncertainties by an average of 22%; where the correction in bins with better photometry is less; while the correction in bins with poor photometry (i.e., high redshift and/or low mass) can be as much as 50%. Note that these uncertainties account for both instrumental and confusion noise, as well as for any pixel-pixel correlations that map-making may introduce.
Lastly, systematic errors arising from estimating the solid angles (or beam areas) of the MIPS PSFs (Béthermin et al., 2010), as well as calibration uncertainties at all wavelengths (Engelbracht et al., 2007; Gordon et al., 2007; Stansberry et al., 2007; Swinyard et al., 2010), must be taken into account, particularly when estimating the contribution to the CIB from galaxies. These errors are accounted for empirically through inclusion into the Monte Carlo simulation used to estimate the ultimate errors.
4. Results
4.1. Stacked Flux Densities
Stacked flux densities and 1 uncertainties are shown for star-forming and quiescent galaxies in the top and bottom panels of Figure 5, and listed in Tables 4 and 5, respectively. We find statistically significant signals in the majority of the bands and bins, with the noisiest signals from bins of lowest masses and highest redshifts, and the most robust signals in those of the higher mass bins. Also, as expected from the beam size and noise properties of the maps, the MIPS 24m and three SPIRE bands return stacked flux densities with the highest signal-to-noise, while the 70 and 160m uncertainties are larger. The uncertainties at 1100m are also higher, but that is largely a reflection of the area of the AzTEC field, which is half that of the other bands.
We note that the traditional stacking method, as anticipated from simulations (§ 3.3), returns systematically higher results, with the bias proportional to the strength of the clustering, which increases with increasing stellar mass. Considering this trend, any method that applies one correction for all stacked results should be viewed with suspicion.
Also notable is the significant contribution from galaxies identified as quiescent by their colors, a signal which is most prominent from the galaxies in the highest redshift bins. Their flux densities in all bands increase steadily with increasing redshift, to the point where at , they are comparable to those of the most massive star-forming galaxies in the sample. It is likely that this is the result of misclassification of star-forming galaxies arising from low signal-to-noise photometry scattering their colors into the quiescent plane of the UJV diagram. We discuss this and other scenarios in § 5.2.
4.2. Best-Fit SEDs

Intensities, , are estimated from stacked flux densities and plotted in Figure 6 with detections shown as circles, while non-detections are shown as 2 upper limits. Stacked flux densities trace out the SED of thermally emitting warmed dust. While the shape of the SED is a superposition of many blackbody emitters of different temperatures (e.g., Wiebe et al., 2009), it has been shown to be well modeled as a modified blackbody of the form;
| (12) |
where is the blackbody spectrum (or Planck function) with amplitude , and is the emissivity index. The mid-infrared exponential on the Wien side of the spectrum can be replaced with a power-law of the form , which is added by specifically requiring that the two functions and their first derivatives be equal at the transition frequency. Values for both and in the literature range from 1.5 to 2 (e.g., Blain et al., 2003; Dunne et al., 2011; Viero et al., 2012), while we use and , which represent the mean values of the best fits of the individual SEDs. Note that for both and , we check that the exact values chosen does not significantly bias the result.
Our SED fitting procedure estimates the amplitude and temperature of the above template. For the SPIRE points, the SED fitting procedure (described in detail in Chapin et al., 2008) takes the width and shape of the photometric bands into account, as well as the absolute photometric calibration uncertainty in each band. Correlations due to instrumental noise are estimated and accounted for with a Monte Carlo procedure.
Correlated confusion noise must also be accounted for in the fit, as these correlations reduce the significance of a detection in single band. That is, not accounting for correlated noise in the measurements of, say, the three SPIRE bands, would lead to attributing additional weight in the overall fit to these data, potentially leading to a bias. This is discussed in more detail in Moncelsi et al. (2011) and Viero et al. (2012). We estimate the Pearson coefficients of the correlation matrix for all bands from the beam-convolved maps (Table 2).
| Band | ||||||||
|---|---|---|---|---|---|---|---|---|
| (m) | 24 | 70 | 100 | 160 | 250 | 350 | 500 | 1100 |
| 24 | 1 | 0.23 | 0.33 | 0.32 | 0.28 | 0.17 | 0.07 | 0.10 |
| 70 | 1 | 0.19 | 0.24 | 0.23 | 0.14 | 0.06 | 0.08 | |
| 100 | 1 | 0.28 | 0.21 | 0.11 | 0.04 | 0.05 | ||
| 160 | 1 | 0.35 | 0.23 | 0.10 | 0.13 | |||
| 250 | 1 | 0.37 | 0.18 | 0.28 | ||||
| 350 | 1 | 0.20 | 0.33 | |||||
| 500 | 1 | 0.23 | ||||||
| 1100 | 1 |
Interquartile errors, which reflect the uncertainty in dimming due to the width of the redshift bins, are estimated from the distribution of redshifts over the full set of simulated catalogs generated as described in § 3.4. Best-fit SEDs for each mass and redshift bin are shown in Figure 6 as solid blue lines; dotted blue lines and shaded regions represent the interquartile errors.
The best-fit SEDs serve several purposes. The first, and our primary purpose, is to infer the contribution from galaxies in each bin to the entire CIB (spanning the full range of wavelengths of our sample). Another purpose is to estimate infrared luminosities, as described in Kennicutt (1998), by integrating the SED between rest-frame 8 and 1000m (shown as horizontal yellow dotted lines in panels of Figure 6). These are later used when quantifying the contribution to the CIB from galaxies classified as “normal”, luminous, and ultra-luminous infrared galaxies (§ 4.6). Infrared luminosities can be used as an indicator of obscured star formation, a topic that will be explored in Arumugam et al. (in prep.). Finally, best-fit SEDs give a measure of the effective dust temperatures, which we discuss in § 4.7. For reference, both temperatures and luminosities are listed in the panels of Figure 6.
4.3. Total Resolved CIB
We estimate the contribution to the CIB from our K-selected galaxy sample (first without correcting for incompleteness) by multiplying the emission from each bin () by the number of galaxies in that bin, and summing them together. Results are tabulated in the second column of Table 3, labeled ‘Total Stacking’.
Next, corrections for incompleteness are made for samples that are more than 50% complete, by dividing each bin by its completeness estimate (drawn from Figure 2) before summing. Results are tabulated in the third column of Table 3, labeled ‘Completeness Corrected’. The choice of 50%, though somewhat arbitrary, is chosen because at that point the uncertainty in the incompleteness estimate is not yet greater than the correction. Note that the uncertainties associated with this correction are accounted for as part of the Monte Carlo simulation used to estimate the total uncertainties. We find that the completeness correction adds between –3% to the total CIB. If we relax the completeness requirement and correct bins which are as little as 10% complete, the completeness correction rises to –15% and the resolved CIB to 97% in the SPIRE bands. Although hardly robust, this at least suggests that some fraction of the remaining CIB originates from faint sources. This scenario is discussed in more detail in § 5.4.1. In all subsequent CIB figures, plotted points are completeness-corrected unless otherwise noted, with the total contribution in each band plotted as pink squares.
Also plotted are estimates of the total CIB as measured by: Spitzer/MIPS at 24m (diamond; Dole et al., 2006); IRAS at 60m (boxes; Miville-Deschênes et al., 2002); Spitzer/MIPS at 24, 70, and 160m (asterisks; Béthermin et al., 2010) as well as at 70 and 160m (exes; Jauzac et al., 2011); WHAM at 100, 140, and 240m (crosses; Lagache et al., 2000); and from COBE/FIRAS spectra spanning to 1200m (solid line; Lagache et al., 2000). Lower limits are shown as upward pointing arrows from Spitzer/MIPS at 24m (Papovich et al., 2004) and at 70 and 160m (Dole et al., 2006); SPIRE at 250, 350, and 500m (Béthermin et al., 2012c); and SCUBA at 450m (Serjeant et al., 2004) and 850m (Smail et al., 2002). Lastly, plotted as lavender asterisks is the resolved CIB using 24m priors from Vieira et al. (in prep.)
As previously described, the relationship between stacked fluxes from different bands is well approximated by a simple thermal dust SED. This can be used to roughly estimate the total resolved CIB between bands, as well as give us a better handle on the contribution from noisy bands. Thus, we estimate the total contribution to the CIB from summing the best-fit SEDs of Figure 6 (corrected for incompleteness), and report them in the fourth column of Table 3, labeled ‘Total Model SEDs’. Comparing these measurements to the absolute CIB values listed in the last column of the same Table, labeled ‘Reference’, we find that our full sample resolves , , , , , , , and at 24, 70, 100, 160, 250, 350, 500, and 1100m, respectively.

| This Work | Absolute Measurements | ||||
|---|---|---|---|---|---|
| Band | Total Stacking | Completeness Corrected | Total Model SEDs | Absolute CIB | Reference |
| () | () | () | () | () | |
| 24 | Béthermin et al. (2010) | ||||
| 70 | Béthermin et al. (2010) | ||||
| 100 | Berta et al. (2011) | ||||
| 160 | Berta et al. (2011) | ||||
| 250 | Lagache et al. (2000) | ||||
| 350 | Lagache et al. (2000) | ||||
| 500 | Lagache et al. (2000) | ||||
| 1100 | Lagache et al. (2000) | ||||
4.4. Contribution to the CIB in Broad Redshift Bins
Plotted as open circles in the top panel of Figure 7 and tabulated in Table 6 are estimates of the contribution to the total resolved CIB in four redshift bins. The dot-dashed lines connecting the circles represent the equivalent summed SED fits. Notable is the striking dependence on the contribution to different bands from different redshifts—a result of negative -correction—with the –1 bin dominating the CIB at m, and the –2 bin the chief contributor at m.
Not surprisingly, as infrared luminosity is a tracer of obscured star formation (e.g., Kennicutt, 1998), this behavior closely mimics the rapid rise in the star-formation history of the universe (e.g., Hopkins & Beacom, 2006; Behroozi et al., 2013b), peaking at , as well as the same general trends as the model predictions of Béthermin et al. (2011, top panel of figure 11), though it should be noted that the limits of the redshift bins are not identical. We explore similarities with models and agreement with measurements of the infrared luminosity density further in § 4.6.
4.5. Contribution to the CIB in Stellar-Mass Bins
We estimate the contribution to the CIB in divisions of stellar mass by summing completeness-corrected emission in rows of Figure 6, with star-forming and quiescent galaxies grouped separately, and tabulated in Tables 7 and 8, respectively. They are also shown in the bottom panel of Figure 7 as color-coded stars and circles (quiescent galaxies are all grouped together), with the dot-dashed lines representing the equivalent summed SED fits.
A significant part of the resolved CIB () at all wavelengths appears to originate from star-forming galaxies having stellar masses between log(–11.0. The total contribution from more massive galaxies is %, while that from less massive galaxies is 30%. Galaxies from the log(–10.5 bin provide the highest contribution everywhere; while those from the log(–11.0 bin provide second highest contribution at m, and those from the log(–10.0 bin provide the second highest contribution at shorter wavelengths. Quiescent galaxies together, unsurprisingly, contribute very little to the total resolved background, of order 5%.
Galaxies form in dark matter over-densities, or halos (e.g., Mo & White, 1996), with the peak efficiency for star formation in halos of log( (e.g., Moster et al., 2010; Behroozi et al., 2010; Béthermin et al., 2012b; Viero et al., 2013b), which appears to be remarkably consistent throughout the age of the Universe (Behroozi et al., 2013a). On the other hand, the stellar mass of the galaxies which formed in these halos, and the evolution of that relationship, is less certain. Wang et al. (2013) found stellar-to-halo mass values of to from to to 2, which equates to log( to 10.6, largely consistent with our findings. We explore the luminosity density evolution of these same galaxies in the next section.
4.6. Contribution to the CIB as a Function of Galaxy Luminosity
Infrared luminosities, , are calculated by integrating the rest-frame SEDs between 8 and 1000m (Kennicutt, 1998). In Figure 8 we plot as a function of redshift, in divisions of stellar mass, with star-forming and quiescent galaxies displayed as stars and circles, respectively, and open symbols represent bins whose completeness is greater than 50%. Infrared galaxies have conventionally been classified by their luminosities into “normal” (), luminous (LIRG: ) and ultra-luminous (ULIRG: ) infrared galaxy classes, illustrated in Figure 8 as horizontal dotted lines and right-handed labels.
We fit simple polynomials to vs. z to each stellar-mass bin, , such that
| (13) |
following the rule that the i variables of each must additionally obey their own polynomial fit,
| (14) |
where the order of the polynomial fit, , is 2 and 1 for star-forming and quiescent galaxies, respectively. This simple parameterization ties together the evolution of the luminosity with stellar mass and redshift, and allows us to fully explore the L–M–z space888The fitting functions to produce these curves are made available online.. We find
We find a rapid rise of luminosity with redshift for the most massive populations, and an apparent turnover at in the less massive ones; though we caution that incompleteness makes this turnover effect difficult to interpret. Particularly striking is the evolution of the luminosities of quiescent galaxies, since at lower than they are barely detectable, while by they are nearly as luminous as star-forming galaxies of similar mass. This is likely partially due to misclassification of star-forming galaxies arising from low signal-to-noise photometry at high redshift scattering galaxies into the quiescent part of the UVJ plane. Note that although the most massive galaxies at high redshift are very luminous, they make up a relatively small fraction of the full catalog and thus contribute only of the total resolved CIB (see § 4.5, and bottom panel of Figure 7). It is possible that some fraction of the dust heating is due to active galactic nuclei (AGN), as similar behavior has been seen in individually resolved objects at 24m (e.g., Pérez-González et al., 2008b; Marchesini et al., 2010), though the optical SEDs of this population on average are not indicative of AGN. These scenarios are discussed in more detail in § 5.2 and § 5.3.
Also shown are 24m-selected stacking results from (Pascale et al., 2009, cyan crosses) and Vieira et al. (in prep., lavender asterisks). Their selection groups together galaxies of all masses and colors making a direct comparison difficult, yet the general trend of both stacks seem to agree reasonably well.


In Figure 9 we explore the contribution to the infrared luminosity density (; e.g., Hopkins & Beacom, 2006; Le Floc’h et al., 2005; Rodighiero et al., 2010; Behroozi et al., 2013b) in divisions of stellar mass and color. Again, star-forming and quiescent galaxies are displayed as stars and circles, respectively, and open symbols represent bins with greater than 50% completeness. We find that the contribution from the most massive galaxies (which we have already found account for less than 4% to the total CIB) evolves rapidly with redshift, such that by they are responsible for as much as their more abundant, less massive counterparts—a clear demonstration of downsizing (e.g., Cimatti et al., 2006; Fontanot et al., 2009).
Plotted as pink squares is the total , as well as a model prediction for the star-formation rate density (SFRD) from Behroozi et al. (2013b), converted to luminosity density using the Kennicutt (1998) relation
| (17) |
with an additional lowering by 0.23 dex to convert to a Chabrier (2003) initial mass function (e.g., Kriek et al., 2009). Equivalent values for the SFRD are shown for reference on the right-hand axis of Figure 9. We find relatively good agreement with the model, which is also in agreement with a host of different measurements (e.g., Rodighiero et al., 2010; Pérez-González et al., 2008a; Le Floc’h et al., 2005; Caputi et al., 2007; Casey et al., 2012; Burgarella et al., 2013; Magnelli et al., 2013) and models (e.g., Hopkins & Beacom, 2006).
In Figure 10 we explore the contribution to the CIB from “normal” galaxies, LIRGs, and ULIRGs. Data are constructed by summing intensities of bins corresponding to their luminosities as determined from the best-fit SEDs (§ 4.2). Short of 160m, the contribution from LIRGs and less-luminous galaxies is comparable, while at wavelengths longer than 160m, LIRGs clearly dominate the resolved CIB. The contribution from log( galaxies falls rapidly at wavelengths greater than 160m, which may suggest a diminishing contribution from fainter populations at high redshift—which is again suggestive of downsizing—but it could also mean that fainter galaxies are simply being missed. The contribution from ULIRGs, which, as seen from Figure 8, are located at , peaks at longer wavelengths, and is an order of magnitude lower than less-luminous galaxies at m. Note that if small numbers of exceptionally luminous sources, ultra-luminous or hyper-luminous infrared galaxies, have unusually high luminosities with respect to their stellar masses (i.e., high specific luminosities) this plot would fail to capture their distribution accurately.
Also overlaid in this figure are predictions from Béthermin et al. (2011, bottom panel of Figure 11), a parametric backwards-evolution model fit to counts at multiple wavelengths. The general trends are well reproduced, while in detail, ULIRGs fall short of model predictions. As we discuss § 5.4.2, this may be an indication that highly dust-obscured galaxies are missing from our optical/NIR-based, mass-selected catalog (e.g., Dey et al., 1999).

4.7. Average Temperature Evolution for Star-Forming Galaxies

In Figure 11 we plot temperatures derived from our best-fit SEDS as a function of redshift (left panel), infrared luminosity (center panel), and stellar mass (right panel) for star-forming galaxies divided into stellar-mass (left panel) or redshift bins (center and right panels). We emphasize that the reported temperatures are tied to the simple modified blackbody used to derive them (§ 4.2), and that if another model had been used (e.g., a value of 1.5 instead of 2, a different opacity model, or a two component SED similar to that used by Dunne & Eales, 2001), slightly different temperature values would have been derived (also see Casey, 2012). However, the trends in the temperatures—either with redshift or with mass—should be relatively free of bias due to the model adopted. Moreover, since our relatively high signal-to-noise measurements bracket the peak of the thermal SED, our ability to identify these trends is robust.
We compare with temperature measurements of other galaxies—some FIR-selected, others NIR-selected— noting that because our sample is mass-selected, we anticipate there to be discrepancies due to the selection functions of the different sets of galaxies. In the leftmost panel we see a clear trend of an increase of temperature with redshift for galaxies of all stellar masses. This trend is also seen in stacked measurements from Pascale et al. (2009, pink exes), from submillimeter-selected galaxies from Amblard et al. (2010, asterisks) and Elbaz et al. (2010, crosses), and Spitzer-selected galaxies from Kovács et al. (2010, triangles). The systematic offset of our mass-selected sample from these may partly be a result of the model fitted, and partly due to the fact that IR-selected sources will consequently be more luminous.
Following Addison et al. (2013), we fit the function
| (18) |
where and are the pivot temperature and redshift, respectively. This simple relationship is central to current halo models of the CIB (e.g., Addison et al., 2013; De Bernardis & Cooray, 2012; Shang et al., 2012; Viero et al., 2013b), yet remains poorly constrained, with values ranging from (Viero et al., 2013b, Model 2) to (Addison et al., 2013) . We find , in good agreement with the CIB models presented in Viero et al. (2013b, Model 3) and the Planck Collaboration et al. (2013).
In the central panel we explore the well established Luminosity–Temperature (L–T) relation (e.g., Dunne et al., 2000, 2011; Dunne & Eales, 2001; Dale et al., 2001; Dale & Helou, 2002; Chapman et al., 2003a; Chapin et al., 2009; Hwang et al., 2010; Magdis et al., 2010; Roseboom et al., 2012; Magnelli et al., 2013), comparing to relations measured by Chapman et al. (2003b, green dashed line), Roseboom et al. (2012, orange dashed line), Dye et al. (2009, blue dashed line), and Amblard et al. (2010, grey dashed line), along with NIR-selected galaxies from Magdis et al. (2010, crosses), and FIR-selected galaxies from Casey et al. (2012, exes) and Symeonidis et al. (2013, triangles).
We find poor agreement with the shallow slopes of Dye et al. (2009) and Amblard et al. (2010), which may be a reflection of the shallow nature of the submillimeter data used in those studies (i.e., BLAST and H-ATLAS, respectively), as well as the selection criteria (e.g., 3 detections in three SPIRE or PACS bands plus a 5 detection in SDSS or GAMA). On the other hand, we find generally good agreement with the trends reported locally in Chapman et al. (2003b) and at higher redshift by Roseboom et al. (2012); with overall values better described by the latter. We also find that our measurements are consistent with the mean values of resolved, SPIRE-selected sources from Casey et al. (2012), but that they are offset from those of Symeonidis et al. (2013).
However, we notice that our incomplete bins (filled stars) have systematically higher temperatures, suggesting that incomplete samples in the optical/NIR select hotter sources. This appears to be the case for the sources selected at NIR wavelengths by Magdis et al. (2010). This could also then mean that the selection criterion of Symeonidis et al. (2013, 24m sources with 3 detections at 160m and either 100 or 250m) favors sources with higher temperatures—in contrast to the missing “hot dust” ULIRG bias typically associated with submillimeter to millimeter sources (e.g., Eales et al., 2000; Blain et al., 2004; Chapman et al., 2004, 2008; Casey et al., 2009; Magdis et al., 2010; Magnelli et al., 2010; Hayward et al., 2012). Again, the small discrepancies between these different measurements is likely attributable to a combination of selection effects and model-based systematic bias (see also Magnelli et al., 2012).
Also of note in the central panel of Figure 11 is that in any one redshift bin the temperature appears to decrease somewhat with increasing luminosity. Similarly, in the rightmost panel we see that the temperature decreases for increasing stellar mass—particularly at lower redshifts—which follows since stellar mass and luminosity are strongly correlated (Figure 8). We explore the evolution of temperature with stellar mass and redshift by fitting the relations with tied power-law fits, i.e.,
| (19) |
where power laws must obey the rule that the amplitudes and slopes of the fits are also fit by power laws
| (20) | |||
| (21) |
where and , which amounts to steady increase of temperature with redshift, a mild anti-correlation of temperature with stellar mass, but a negligible change of the slope of the anti-correlation over time.
There are several possible explanations for this apparent anti-correlation between stellar mass and temperature. Dust creation is thought to be dominated by supernovae (SNe), and to a lesser extent, evolving main sequence stars on the asymptotic giant branch (AGB; e.g., Michałowski et al., 2010a, b). Since infrared luminosity (an established proxy for star-formation rate; e.g., Kennicutt, 1998) and dust mass (e.g., Santini et al., 2010; Skibba et al., 2011) are strongly correlated with stellar mass, it follows that there would be more dust extended over a larger volume in more massive galaxies (e.g., Menéndez-Delmestre et al., 2009). Also plausible is the possibility that less massive galaxies are more susceptible to stripping of their gas and dust (e.g., Abadi et al., 1999; McCarthy et al., 2008), which Rawle et al. (2012) show, can lead to higher temperatures.
Thus, our findings appear to be in tension with the local (L–T) relation for SMGs, which may again be a function of the stellar-mass selection vs. far-infrared selection. Case in point: Hayward et al. (2013) show that galaxies with temperatures above roughly 40 K are universally starbursts (e.g., Hernquist, 1989) as opposed to quiescently star forming (e.g., Davé et al., 2010). As we already showed in § 4.6 and Figure 10, there are indications that this is exactly the population that is being missed.
4.8. Redshift Distribution of the Resolved CIB
The redshift distribution of the resolved CIB emission, , is measured by summing the completeness-corrected intensities of all stellar-mass bins separately in each band, and is plotted Figure 12 as upward pointing triangles, signifying that they are lower limits. The peak intensities shift from –2 with increasing wavelength, indicative of the peak of star formation occurring at –2 (e.g., Hopkins & Beacom, 2006; Behroozi et al., 2013b; Wang et al., 2013), and the redshift sensitivity of the different bands.
Also plotted are predictions for the entire CIB from a selection of recently published models. The Béthermin et al. (2012a) model in particular, which is based in part on stacking measurements with 24m priors (Béthermin et al., 2012c), describes the measured distribution extremely well. However, we caution that since the completeness is a strong function of redshift (see Figure 2), it is not expected that the remaining CIB be distributed evenly in redshift.
This measurement has multiple applications. For example, CIB anisotropy measurements (e.g., Lagache et al., 2007; Viero et al., 2009; Hall et al., 2010; Viero et al., 2013b; Amblard et al., 2011; Planck Collaboration et al., 2011, 2013) are typically interpreted with halo models (e.g., Peacock & Smith, 2000; Cooray & Sheth, 2002), which assign intensities to dark matter halos a function of halo mass, redshift, and SED of thermal dust emission. These models find significant degeneracies between SEDs and the redshift distribution of the CIB (e.g., Addison et al., 2012; Shang et al., 2012), or halo bias and redshift distribution of the CIB (e.g., Holder et al., 2013), limiting their interpretive power. The measurements of reported here, as well as the T-M-z dependence of the thermal SED from § 4.7, provide powerful constraints for future models.

5. Discussion
5.1. Incompleteness Bias
The simstack technique returns an unbiased estimate of the flux density when all potentially correlated sources are accounted for. When sources are missing, either because they are too dust-obscured or intrinsically faint to detect, their unaccounted-for flux may potentially bias the result. While the UDS is an exceptionally deep survey, with greater than 90% completeness at and log(, it is possible that the absence of lower-mass galaxies, particularly at higher redshifts, could affect the results. We explore the severity of a potential bias with the following simulation.
Restricting ourselves to star-forming galaxies, we first simultaneously stack all mass bins at a single redshift and record their fluxes. Next, we remove the lowest mass bin and stack again, comparing the fluxes in the remaining bins to those of the initial stacked fluxes. We repeat this until only the highest mass bin remains. Results are as we might expect: the removal of bins increases the stacked fluxes of the remaining bins in a systematic way, from negligibly little for one missing bin, to as much as 3-22% for the highest-mass bin alone; and that the level of the bias increases with beam size. For the case of two mass bins removed—roughly equivalent to the scenario of our highest redshift bin—the bias ranges over 0.2–4.0%, from smallest to largest beam size.
What does this mean for resolving the background? Although missing sources boost the fluxes of those remaining, the sum of their missing flux counteracts the boosting, resulting in a marginal bias. Our simulations confirm this, with the removal of up to three bins having negligible impact.
5.2. Contribution from Quiescent Galaxies
Here we briefly discuss the small contribution () to the total resolved CIB from galaxies classified as quiescent. The majority of this contribution originates at , in contrast with the rest of the CIB, which comes mostly from star-forming galaxies at –2. Indeed, at the most massive quiescent galaxies () are ULIRGs, and the next most massive () are LIRGs.
The simplest explanation is that star-forming galaxies are being misclassified as quiescent galaxies, particularly at , where their signal-to-noise in the optical is lower, and their colors thus more likely to be scattered into the quiescent part of the UVJ plane. But dig a little deeper and that scenario alone seems unlikely, as to achieve ULIRG-like luminosities on average, either all quiescent galaxies at the highest redshifts must be misclassified ULIRGS—i.e., no passive quiescent galaxies past redshift of —or that the fraction that is misclassified would need to be incredibly luminous and abundant (e.g., – for 50% contamination, – for 25% contamination, etc.); both of which would be wildly inconsistent with the latest measurements of the stellar mass function (Muzzin et al., 2013a; Ilbert et al., 2013).
Alternatively, it might be that interlopers misclassified in redshift as well as color are boosting the flux. This would result in a slightly hotter SED in the rest frame—which we do see—and significant boosting of without the need for excessively luminous sources. However, we have already seen that as a result of negative -correction, flux densities are roughly flat with redshift in the submillimeter bands (e.g., Figure 5), so that only relatively local (i.e., ) sources would be capable of boosting the flux densities enough to account for the increased luminosities. But as that is also where photo- are most reliable (e.g., Brammer et al., 2008; Quadri & Williams, 2010), it unlikely that this is taking place.
Aside from measurement errors, it is worth noting that there are possible physical explanations for the FIR emission. Because the star formation in quiescent galaxies can only have shut off very recently at these redshifts, there may still be a strong interstellar radiation field heating the dust. For example, Fumagalli et al. (2013) explore whether not supposedly quiescent galaxies (also selected with the UVJ technique) are indeed dead. They split up their sample into five redshift bins and select only quiescent galaxies with stellar masses greater than log(, finding log(–10.5 over the redshift range . These luminosities are largely consistent with our findings—both in amplitude and in the evolution of that amplitude—but fall short of the redshift range where we find passive galaxies with ULIRG-like luminosities. They conclude that circumstellar dust from AGB stars (e.g., Knapp et al., 1992; Lançon & Mouhcine, 2002; Piovan et al., 2003), and cirrus heated by old stellar populations (e.g., the so-called cirrus heating Kennicutt, 1998; Salim et al., 2009), are probably responsible for much of the IR emission in their sample, and that the star-formation rates in these galaxies is some 20–40 times lower than in their star-forming counterparts.
Another possibility is that there is FIR emission associated with embedded AGN in highly obscured red galaxies at high redshift (e.g., Polletta et al., 2006, 2008; Daddi et al., 2007; Alexander et al., 2008; Kirkpatrick et al., 2012). AGN are found to have luminosities log(–13 at (e.g., Pope et al., 2008; Dai et al., 2012), which would be enough to explain the rising luminosity with redshift, particularly since the evolution of the AGN fraction follows a similar trend (e.g., Alexander et al., 2005). We explore this scenario in more detail in the next section.
Finally, it might just be possible that increasing levels of star formation is present but so heavily obscured that the contribution from young stars to the rest-frame J-band luminosity is small. There are examples of high-redshift passive galaxies with 24m flux suggesting excess FIR emission, (e.g., Marchesini et al., 2010; Pérez-González et al., 2008b); as well as optically selected red-and-dead galaxies stacked in the submillimeter showing excess flux, possibly indicating star-formation (Viero et al., 2012).
5.3. Active Galactic Nuclei and the High Sample
AGN have been found to contribute to the infrared luminosities of both passive and star-forming galaxies at levels between 3 and 37% (e.g., Pope et al., 2008; Mullaney et al., 2011; Juneau et al., 2013). While submillimeter colors alone are inadequate for identifying AGN (e.g., Hatziminaoglou et al., 2010; Kirkpatrick et al., 2013), the mid-infrared has been established as a sensitive probe of galaxy type (e.g., Brandl et al., 2006; Farrah et al., 2007), with the presence of an exponentially rising SED a robust signature of AGN (Lacy et al., 2004; Richards et al., 2006; Hickox et al., 2007; Assef et al., 2010; Mullaney et al., 2011; Stern et al., 2012; Feltre et al., 2013). When spectra are not available, it has been shown that higher 22–24m flux densities correlate with higher AGN fractions (Daddi et al., 2007; Lee et al., 2010; Murphy et al., 2011; Bridge et al., 2013).
We look for evidence of AGN in the roughly 2,700 sources that were otherwise poorly fit with standard SEDs by adding an AGN template (e.g., Assef et al., 2010) to the fit, and find that approximately half of the fits are significantly improved. Next, we stack them separately from—but simultaneously with—the star-forming and quiescent galaxies to look for further indications of AGN. We find that the contribution to the CIB from these sources is , and is distributed over the same redshift range as the star-forming galaxies. Additionally, we find that the SEDs are on average hotter, an indication that emission from hot dust around the AGN (e.g., Rowan-Robinson & Crawford, 1989; Lacy et al., 2004) is contributing to the thermal SED at shorter wavelengths Kirkpatrick et al., 2012, (e.g.,Feltre et al., 2013, ; although also see). We also find that the 24m flux density exceeds that of the other galaxies of similar mass, again, a strong signature of AGN (e.g., Daddi et al., 2007; Lee et al., 2010).
While intriguing, fully understanding the contribution from AGN is complicated and subtle, and lies beyond the scope of this paper. It is worth noting that because AGN emission should exist at varying levels in all galaxies (e.g., Juneau et al., 2013), the total contribution to the CIB attributable to AGN may in fact be significant. A full treatment of this class of sources requires exploring this threshold with better mid-infrared diagnostics and fits using a full set of AGN templates will be explored in detail in Moncelsi et al. (in prep.).
5.4. Where is the Missing CIB?
Based on our best-fit SEDs, we resolve , , , , , , , and at 24, 70, 100, 160, 250, 350, 500, and 1100m, respectively. This accounts for between ()% and ()% of the CIB, with the lowest fractions resolved at the longest (AzTEC) wavelengths, and the highest fractions in the three SPIRE bands. This is similar to the resolved fraction found by Marsden et al. (2009)—although they likely suffered from a bias due to neglecting clustering within the large BLAST beams (Pascale et al., 2008)—and by Vieira et al. (in prep.) and Béthermin et al. (2012c) at far-infrared/submillimeter wavelengths.
Between % and % of the CIB thus appears to be unaccounted for by our K-selected sample. It is notable that the measurements for the absolute CIB are themselves uncertain at the level, so that formally our measurements could be said to be consistent with the CIB in any one band. However, considering that they fall below the nominal CIB in every band, the quoted percentage should be a fair estimate.
Besides the possibility that the absolute CIB is not entirely of extragalactic origin, the two most obvious candidates for the missing fraction are: 1) a large number of low-mass, intrinsically faint sources undetected by the UDS survey; and 2) IR luminous, potentially massive but unusually dust-obscured sources also missed by the UDS selection. We will now discuss these possibilities.
5.4.1 Low-Mass Faint Sources
Our sample is selected at , reaching a source density on the sky of . Fainter, lower-mass sources missed by the catalog certainly exist (i.e., the faint end of the luminosity function, e.g., Muzzin et al., 2013a; Ilbert et al., 2013), but could they contribute enough intensity to make up the remaining CIB?
If we assume that there are as many undetected sources as there are detected, and that at, say, 500m, their flux densities are 0.1 mJy (i.e., just below that of the current lowest mass bin) at all redshifts (not unreasonable given negative -correction, e.g., see Figure 5), that would add , i.e., another , to the CIB. This behavior mirrors the behavior demonstrated in § 4.3, where aggressively correcting for completeness brought the CIB to within 5% of the nominal total. We thus conclude that some fraction is probably due to the faint population, though without a full simulation, or deeper data, it is difficult to say how much.
5.4.2 Dust-Obscured Sources
There exists sources—for example submillimeter galaxies—that are incredibly luminous in the infrared (e.g., ) but so dust-obscured that they are often very faint at UV/optical wavelengths (Smail et al., 1997; Barger et al., 1998; Hughes et al., 1998; Blain et al., 2002). For example, Dey et al. (1999), observing a log( ULIRG at with the Wide Field Planetary Camera 2 (WFPC2; Holtzman et al., 1995) on the Hubble Space Telescope with the F814W filter () measured a magnitude of [AB]; i.e., this source would probably not have made our cut. These sources tend be irregular galaxies—likely due to a recent or ongoing merger (Hernquist, 1989; Hayward et al., 2013)—forming stars in bursts rather than at a steady rate governed by the infrared “main sequence” for star-forming galaxies (e.g., Noeske et al., 2007; Elbaz et al., 2011).
A hint that luminous but obscured sources might be going undetected comes from Figure 10, where the resolved fraction of ULIRGs is in disagreement with the Béthermin et al. (2011) model, while less-luminous sources appear to be in quite good agreement. Since the sum of the three colored curves resolves the full CIB, it may well be that this missing component is rather significant.
Likely better tracers of highly dust-obscured star-forming galaxies are 24m sources, which, as already mentioned, have been used by several groups as positional priors. For example, Dole et al. (2006) found that 24m selected sources make up 70% of the CIB at 70 and 100m; while Berta et al. (2011) found they could explain between 58 and 64% of the CIB at 100 and 160m; and Béthermin et al. (2012c) resolve 70% of the background at 250, 350, and 500m. However, a considerable fraction of the emission at 24m is shown to originate from galaxies hosting AGN (e.g., Vieira et al. in prep.).
As we discussed in § 5.3, the inclusion of high sources increased the stacked 24m flux density more than at other bands. And although we resolve about the same amount of the CIB, it does not mean we are resolving the same sources. It is possible that other faint AGN are being missed, particularly at high redshift, where the AGN contribution dominates. The potential thus exists that we are missing a significant contribution from dust-obscured galaxies. In the future, identifying 24m and other sources missed by our K-selected catalog—and stacking them simultaneously with our optically selected sources—would be a natural extension of this work.
6. Summary
A complete understanding of galaxies and galaxy evolution requires characterizing their full SEDs, a goal which has to-date been technically challenging, as galaxies in the submillimeter are mostly unresolved. And for those that are resolved, large instrumental beams makes counterpart identification laborious. Here we attempted to statistically connect galaxies selected in the K-band to those that make up the CIB by stacking sources grouped into bins of mass, redshift, and color—presenting and making public our own simstack algorithm.
We found that between ()% and ()% of the total CIB is resolved by our catalog, and that the bulk originates from –2 and log(–11.0. Sources at higher redshifts contribute more at longer wavelengths, a consequence of the peak of the SED redshifting into the submillimeter/millimeter bands (i.e., negative -correction). Higher-mass LIRGs and ULIRGs are seen to contribute at longer wavelengths (i.e., higher redshift), which shifts to lower mass LIRGs and “normal” star-forming galaxies at shorter wavelengths.
We find that the luminosities of all galaxies rises rapidly with increasing redshift, but whereas they continue to rise until for the most massive galaxies, there is an apparent turnover at in galaxies of log(. We further find that while galaxies identified as quiescent by their colors have very little emission at low redshift, beyond they evolve even more rapidly than their star-forming counterparts. This is likely due, to some extent, to limitations in the UVJ color selection at higher redshifts resulting from noisy photometry, though the origin of the entirety of this flux is still not certain, and will be the subject of future work. Lastly, galaxies whose photometry is poorly fit by standard SEDs appear to have a clear association with AGN; having comparable luminosities but higher temperatures as star-forming galaxies of the same stellar mass.
Our work pushes the boundaries of characterizing low mass and high-redshift optical galaxies in the far-infrared/submillimeter, but nevertheless, more can be done. Though the UDS is quite deep, deeper and/or wider fields and new catalogs are now coming online (e.g., Muzzin et al., 2013b; Ilbert et al., 2013; Viero et al., 2013a). That, combined with future ancillary data over large areas and to longer wavelengths, and with deeper near-infrared imaging and 24m catalogs, should allow us to reach the coveted goal of resolving the full cosmic background.
Acknowledgments
The authors warmly thank Duncan Hanson, Phil Korngut, Zak Staniszewski, and Yoshihiro Ueda. We also thank the anonymous referee, whose careful comments greatly improved this paper. Much credit belongs to C. Barth Netterfield and Enzo Pascale for inspiring the simultaneous stacking algorithm, and to whom we are thankful. SPIRE has been developed by a consortium of institutes led by Cardiff Univ. (UK) and including: Univ. Lethbridge (Canada); NAOC (China); CEA, LAM (France); IFSI, Univ. Padua (Italy); IAC (Spain); Stockholm Observatory (Sweden); Imperial College London, RAL, UCL-MSSL, UKATC, Univ. Sussex (UK); and Caltech, JPL, NHSC, Univ. Colorado (USA). This development has been supported by national funding agencies: CSA (Canada); NAOC (China); CEA, CNES, CNRS (France); ASI (Italy); MCINN (Spain); SNSB (Sweden); STFC, UKSA (UK); and NASA (USA). RJA was supported by Gemini-CONICYT grant number 32120009.
References
- Abadi et al. (1999) Abadi, M. G., Moore, B., & Bower, R. G. 1999, MNRAS, 308, 947
- Addison et al. (2013) Addison, G. E., Dunkley, J., & Bond, J. R. 2013, MNRAS
- Addison et al. (2012) Addison, G. E., Dunkley, J., Hajian, A., Viero, M., et al. 2012, ApJ, 752, 120
- Alexander et al. (2008) Alexander, D. M., Chary, R.-R., Pope, A., Bauer, F. E., et al. 2008, ApJ, 687, 835
- Alexander et al. (2005) Alexander, D. M., Smail, I., Bauer, F. E., Chapman, S. C., et al. 2005, Nature, 434, 738
- Amblard et al. (2011) Amblard, A., Cooray, A., Serra, P., Altieri, B., et al. 2011, Nature, 470, 510
- Amblard et al. (2010) Amblard, A., Cooray, A., Serra, P., Temi, P., et al. 2010, A&A, 518, L9+
- Assef et al. (2010) Assef, R. J., Kochanek, C. S., Brodwin, M., Cool, R., et al. 2010, ApJ, 713, 970
- Austermann et al. (2010) Austermann, J. E., Dunlop, J. S., Perera, T. A., Scott, K. S., et al. 2010, MNRAS, 401, 160
- Barger et al. (1998) Barger, A. J., Cowie, L. L., Sanders, D. B., Fulton, E., et al. 1998, Nature, 394, 248
- Behroozi et al. (2010) Behroozi, P. S., Conroy, C., & Wechsler, R. H. 2010, ApJ, 717, 379
- Behroozi et al. (2013a) Behroozi, P. S., Wechsler, R. H., & Conroy, C. 2013a, ApJ, 762, L31
- Behroozi et al. (2013b) —. 2013b, ApJ, 770, 57
- Berta et al. (2011) Berta, S., Magnelli, B., Nordon, R., Lutz, D., et al. 2011, A&A, 532, A49
- Bertin & Arnouts (1996) Bertin, E. & Arnouts, S. 1996, A&AS, 117, 393
- Béthermin et al. (2012a) Béthermin, M., Daddi, E., Magdis, G., Sargent, M. T., et al. 2012a, ApJ, 757, L23
- Béthermin et al. (2010) Béthermin, M., Dole, H., Beelen, A., & Aussel, H. 2010, A&A, 512, A78
- Béthermin et al. (2011) Béthermin, M., Dole, H., Lagache, G., Le Borgne, D., et al. 2011, A&A, 529, A4
- Béthermin et al. (2012b) Béthermin, M., Doré, O., & Lagache, G. 2012b, A&A, 537, L5
- Béthermin et al. (2012c) Béthermin, M., Le Floc’h, E., Ilbert, O., Conley, A., et al. 2012c, A&A, 542, A58
- Blain et al. (2003) Blain, A. W., Barnard, V. E., & Chapman, S. C. 2003, MNRAS, 338, 733
- Blain et al. (2004) Blain, A. W., Chapman, S. C., Smail, I., & Ivison, R. 2004, ApJ, 611, 725
- Blain et al. (2002) Blain, A. W., Smail, I., Ivison, R. J., Kneib, J.-P., et al. 2002, Phys. Rep., 369, 111
- Bourne et al. (2011) Bourne, N., Dunne, L., Ivison, R. J., Maddox, S. J., et al. 2011, MNRAS, 410, 1155
- Bourne et al. (2012) Bourne, N., Maddox, S. J., Dunne, L., Auld, R., et al. 2012, MNRAS, 421, 3027
- Brammer et al. (2008) Brammer, G. B., van Dokkum, P. G., & Coppi, P. 2008, ApJ, 686, 1503
- Brandl et al. (2006) Brandl, B. R., Bernard-Salas, J., Spoon, H. W. W., Devost, D., et al. 2006, ApJ, 653, 1129
- Bridge et al. (2013) Bridge, C. R., Blain, A., Borys, C. J. K., Petty, S., et al. 2013, ApJ, 769, 91
- Bruzual & Charlot (2003) Bruzual, G. & Charlot, S. 2003, MNRAS, 344, 1000
- Burgarella et al. (2013) Burgarella, D., Buat, V., Gruppioni, C., Cucciati, O., et al. 2013, A&A, 554, A70
- Caputi et al. (2007) Caputi, K. I., Lagache, G., Yan, L., Dole, H., et al. 2007, ApJ, 660, 97
- Casey (2012) Casey, C. M. 2012, MNRAS, 425, 3094
- Casey et al. (2012) Casey, C. M., Berta, S., Béthermin, M., Bock, J., et al. 2012, ApJ, 761, 140
- Casey et al. (2009) Casey, C. M., Chapman, S. C., Beswick, R. J., Biggs, A. D., et al. 2009, MNRAS, 399, 121
- Chabrier (2003) Chabrier, G. 2003, PASP, 115, 763
- Chapin et al. (2008) Chapin, E. L., Ade, P. A. R., Bock, J. J., Brunt, C., et al. 2008, ApJ, 681, 428
- Chapin et al. (2009) Chapin, E. L., Pope, A., Scott, D., Aretxaga, I., et al. 2009, MNRAS, 398, 1793
- Chapman et al. (2003a) Chapman, S. C., Helou, G., Lewis, G. F., & Dale, D. A. 2003a, ApJ, 588, 186
- Chapman et al. (2008) Chapman, S. C., Neri, R., Bertoldi, F., Smail, I., et al. 2008, ApJ, 689, 889
- Chapman et al. (2004) Chapman, S. C., Smail, I., Blain, A. W., & Ivison, R. J. 2004, ApJ, 614, 671
- Chapman et al. (2003b) Chapman, S. C., Windhorst, R., Odewahn, S., Yan, H., et al. 2003b, ApJ, 599, 92
- Chary & Pope (2010) Chary, R. & Pope, A. 2010, ArXiv e-prints
- Cimatti et al. (2006) Cimatti, A., Daddi, E., & Renzini, A. 2006, A&A, 453, L29
- Conselice et al. (2011) Conselice, C. J., Bluck, A. F. L., Buitrago, F., Bauer, A. E., et al. 2011, MNRAS, 413, 80
- Cooray & Sheth (2002) Cooray, A. & Sheth, R. 2002, Phys. Rep., 372, 1
- Daddi et al. (2007) Daddi, E., Alexander, D. M., Dickinson, M., Gilli, R., et al. 2007, ApJ, 670, 173
- Dai et al. (2012) Dai, Y. S., Bergeron, J., Elvis, M., Omont, A., et al. 2012, ApJ, 753, 33
- Dale & Helou (2002) Dale, D. A. & Helou, G. 2002, ApJ, 576, 159
- Dale et al. (2001) Dale, D. A., Helou, G., Contursi, A., Silbermann, N. A., et al. 2001, ApJ, 549, 215
- Davé et al. (2010) Davé, R., Finlator, K., Oppenheimer, B. D., Fardal, M., et al. 2010, MNRAS, 360
- De Bernardis & Cooray (2012) De Bernardis, F. & Cooray, A. 2012, ApJ, 760, 14
- Devlin et al. (2009) Devlin, M. J., Ade, P. A. R., Aretxaga, I., Bock, J. J., et al. 2009, Nature, 458, 737
- Dey et al. (1999) Dey, A., Graham, J. R., Ivison, R. J., Smail, I., et al. 1999, ApJ, 519, 610
- Dole et al. (2006) Dole, H., Lagache, G., Puget, J.-L., Caputi, K. I., et al. 2006, A&A, 451, 417
- Dunne et al. (2000) Dunne, L., Eales, S., Edmunds, M., Ivison, R., et al. 2000, MNRAS, 315, 115
- Dunne & Eales (2001) Dunne, L. & Eales, S. A. 2001, MNRAS, 327, 697
- Dunne et al. (2011) Dunne, L., Gomez, H. L., da Cunha, E., Charlot, S., et al. 2011, MNRAS, 417, 1510
- Dye et al. (2009) Dye, S., Ade, P. A. R., Bock, J. J., Chapin, E. L., et al. 2009, ApJ, 703, 285
- Eales et al. (2000) Eales, S., Lilly, S., Webb, T., Dunne, L., et al. 2000, AJ, 120, 2244
- Elbaz et al. (2011) Elbaz, D., Dickinson, M., Hwang, H. S., Díaz-Santos, T., et al. 2011, A&A, 533, A119
- Elbaz et al. (2010) Elbaz, D., Hwang, H. S., Magnelli, B., Daddi, E., et al. 2010, A&A, 518, L29+
- Engelbracht et al. (2007) Engelbracht, C. W., Blaylock, M., Su, K. Y. L., Rho, J., et al. 2007, PASP, 119, 994
- Ezawa et al. (2004) Ezawa, H., Kawabe, R., Kohno, K., & Yamamoto, S. 2004, in Society of Photo-Optical Instrumentation Engineers (SPIE) Conference Series, Vol. 5489, Society of Photo-Optical Instrumentation Engineers (SPIE) Conference Series, ed. J. M. Oschmann, Jr., 763–772
- Ezawa et al. (2008) Ezawa, H., Kohno, K., Kawabe, R., Yamamoto, S., et al. 2008, in Society of Photo-Optical Instrumentation Engineers (SPIE) Conference Series, Vol. 7012, Society of Photo-Optical Instrumentation Engineers (SPIE) Conference Series
- Farrah et al. (2007) Farrah, D., Bernard-Salas, J., Spoon, H. W. W., Soifer, B. T., et al. 2007, ApJ, 667, 149
- Feltre et al. (2013) Feltre, A., Hatziminaoglou, E., Hernán-Caballero, A., Fritz, J., et al. 2013, MNRAS, 434, 2426
- Fixsen et al. (1998) Fixsen, D. J., Dwek, E., Mather, J. C., Bennett, C. L., et al. 1998, ApJ, 508, 123
- Fontanot et al. (2009) Fontanot, F., De Lucia, G., Monaco, P., Somerville, R. S., et al. 2009, MNRAS, 397, 1776
- Fumagalli et al. (2013) Fumagalli, M., Labbe, I., Patel, S. G., Franx, M., et al. 2013, ArXiv e-prints
- Furusawa et al. (2008) Furusawa, H., Kosugi, G., Akiyama, M., Takata, T., et al. 2008, ApJS, 176, 1
- Glenn et al. (1998) Glenn, J., Bock, J. J., Chattopadhyay, G., Edgington, S. F., et al. 1998, in Society of Photo-Optical Instrumentation Engineers (SPIE) Conference Series, Vol. 3357, Society of Photo-Optical Instrumentation Engineers (SPIE) Conference Series, ed. T. G. Phillips, 326–334
- Gordon et al. (2007) Gordon, K. D., Engelbracht, C. W., Fadda, D., Stansberry, J., et al. 2007, PASP, 119, 1019
- Griffin et al. (2010) Griffin, M. J., Abergel, A., Abreu, A., Ade, P. A. R., et al. 2010, A&A, 518, L3
- Hall et al. (2010) Hall, N. R., Keisler, R., Knox, L., Reichardt, C. L., et al. 2010, ApJ, 718, 632
- Hatziminaoglou et al. (2010) Hatziminaoglou, E., Omont, A., Stevens, J. A., Amblard, A., et al. 2010, A&A, 518, L33
- Hauser & Dwek (2001) Hauser, M. G. & Dwek, E. 2001, ARA&A, 39, 249
- Hayward et al. (2012) Hayward, C. C., Jonsson, P., Kereš, D., Magnelli, B., et al. 2012, MNRAS, 424, 951
- Hayward et al. (2013) Hayward, C. C., Narayanan, D., Kereš, D., Jonsson, P., et al. 2013, MNRAS, 428, 2529
- Heinis et al. (2012) Heinis, S., Buat, V., Béthermin, M., Aussel, H., et al. 2012, MNRAS, 350
- Hernquist (1989) Hernquist, L. 1989, Nature, 340, 687
- Hickox et al. (2007) Hickox, R. C., Jones, C., Forman, W. R., Murray, S. S., et al. 2007, ApJ, 671, 1365
- Hilton et al. (2012) Hilton, M., Conselice, C. J., Roseboom, I. G., Burgarella, D., et al. 2012, MNRAS, 425, 540
- Holder et al. (2013) Holder, G. P., Viero, M. P., Zahn, O., Aird, K. A., et al. 2013, ApJ, 771, L16
- Holtzman et al. (1995) Holtzman, J. A., Hester, J. J., Casertano, S., Trauger, J. T., et al. 1995, PASP, 107, 156
- Hopkins & Beacom (2006) Hopkins, A. M. & Beacom, J. F. 2006, ApJ, 651, 142
- Hughes et al. (1998) Hughes, D. H., Serjeant, S., Dunlop, J., Rowan-Robinson, M., et al. 1998, Nature, 394, 241
- Hwang et al. (2010) Hwang, H. S., Elbaz, D., Magdis, G., Daddi, E., et al. 2010, MNRAS, 409, 75
- Ilbert et al. (2013) Ilbert, O., McCracken, H. J., Le Fèvre, O., Capak, P., et al. 2013, A&A, 556, A55
- Jauzac et al. (2011) Jauzac, M., Dole, H., Le Floc’h, E., Aussel, H., et al. 2011, A&A, 525, A52
- Juneau et al. (2013) Juneau, S., Dickinson, M., Bournaud, F., Alexander, D. M., et al. 2013, ApJ, 764, 176
- Kennicutt (1998) Kennicutt, Jr., R. C. 1998, ARA&A, 36, 189
- Kirkpatrick et al. (2012) Kirkpatrick, A., Pope, A., Alexander, D. M., Charmandaris, V., et al. 2012, ApJ, 759, 139
- Kirkpatrick et al. (2013) Kirkpatrick, A., Pope, A., Charmandaris, V., Daddi, E., et al. 2013, ApJ, 763, 123
- Knapp et al. (1992) Knapp, G. R., Gunn, J. E., & Wynn-Williams, C. G. 1992, ApJ, 399, 76
- Komatsu et al. (2011) Komatsu, E., Smith, K. M., Dunkley, J., Bennett, C. L., et al. 2011, ApJS, 192, 18
- Kovács et al. (2010) Kovács, A., Omont, A., Beelen, A., Lonsdale, C., et al. 2010, ApJ, 717, 29
- Kriek et al. (2009) Kriek, M., van Dokkum, P. G., Labbé, I., Franx, M., et al. 2009, ApJ, 700, 221
- Kurczynski & Gawiser (2010) Kurczynski, P. & Gawiser, E. 2010, AJ, 139, 1592
- Labbé et al. (2006) Labbé, I., Bouwens, R., Illingworth, G. D., & Franx, M. 2006, ApJ, 649, L67
- Labbé et al. (2005) Labbé, I., Huang, J., Franx, M., Rudnick, G., et al. 2005, ApJ, 624, L81
- Lacy et al. (2004) Lacy, M., Storrie-Lombardi, L. J., Sajina, A., Appleton, P. N., et al. 2004, ApJS, 154, 166
- Lagache et al. (2007) Lagache, G., Bavouzet, N., Fernandez-Conde, N., Ponthieu, N., et al. 2007, ApJ, 665, L89
- Lagache et al. (2000) Lagache, G., Haffner, L. M., Reynolds, R. J., & Tufte, S. L. 2000, A&A, 354, 247
- Lagache et al. (2005) Lagache, G., Puget, J.-L., & Dole, H. 2005, ARA&A, 43, 727
- Lançon & Mouhcine (2002) Lançon, A. & Mouhcine, M. 2002, A&A, 393, 167
- Lawrence et al. (2007) Lawrence, A., Warren, S. J., Almaini, O., Edge, A. C., et al. 2007, MNRAS, 379, 1599
- Le Floc’h et al. (2005) Le Floc’h, E., Papovich, C., Dole, H., Bell, E. F., et al. 2005, ApJ, 632, 169
- Lee et al. (2010) Lee, N., Le Floc’h, E., Sanders, D. B., Frayer, D. T., et al. 2010, ApJ, 717, 175
- Levenson et al. (2010) Levenson, L., Marsden, G., Zemcov, M., Amblard, A., et al. 2010, MNRAS, 409, 83
- Lonsdale et al. (2003) Lonsdale, C. J., Smith, H. E., Rowan-Robinson, M., Surace, J., et al. 2003, PASP, 115, 897
- Lutz et al. (2011) Lutz, D., Poglitsch, A., Altieri, B., Andreani, P., et al. 2011, A&A, 532, A90
- Magdis et al. (2010) Magdis, G. E., Elbaz, D., Hwang, H. S., Amblard, A., et al. 2010, MNRAS, 409, 22
- Magnelli et al. (2010) Magnelli, B., Lutz, D., Berta, S., Altieri, B., et al. 2010, A&A, 518, L28
- Magnelli et al. (2012) Magnelli, B., Lutz, D., Santini, P., Saintonge, A., et al. 2012, A&A, 539, A155
- Magnelli et al. (2013) Magnelli, B., Popesso, P., Berta, S., Pozzi, F., et al. 2013, A&A, 553, A132
- Marchesini et al. (2010) Marchesini, D., Whitaker, K. E., Brammer, G., van Dokkum, P. G., et al. 2010, ApJ, 725, 1277
- Marsden et al. (2009) Marsden, G., Ade, P. A. R., Bock, J. J., Chapin, E. L., et al. 2009, ApJ, 707, 1729
- McCarthy et al. (2008) McCarthy, I. G., Frenk, C. S., Font, A. S., Lacey, C. G., et al. 2008, MNRAS, 383, 593
- Menéndez-Delmestre et al. (2009) Menéndez-Delmestre, K., Blain, A. W., Smail, I., Alexander, D. M., et al. 2009, ApJ, 699, 667
- Michałowski et al. (2010a) Michałowski, M. J., Murphy, E. J., Hjorth, J., Watson, D., et al. 2010a, A&A, 522, A15
- Michałowski et al. (2010b) Michałowski, M. J., Watson, D., & Hjorth, J. 2010b, ApJ, 712, 942
- Miville-Deschênes et al. (2002) Miville-Deschênes, M.-A., Lagache, G., & Puget, J.-L. 2002, A&A, 393, 749
- Mo & White (1996) Mo, H. J. & White, S. D. M. 1996, MNRAS, 282, 347
- Moncelsi et al. (2011) Moncelsi, L., Ade, P. A. R., Chapin, E. L., Cortese, L., et al. 2011, ApJ, 727, 83
- Moster et al. (2010) Moster, B. P., Somerville, R. S., Maulbetsch, C., van den Bosch, F. C., et al. 2010, ApJ, 710, 903
- Mullaney et al. (2011) Mullaney, J. R., Alexander, D. M., Goulding, A. D., & Hickox, R. C. 2011, MNRAS, 414, 1082
- Murphy et al. (2011) Murphy, E. J., Chary, R.-R., Dickinson, M., Pope, A., et al. 2011, ApJ, 732, 126
- Muzzin et al. (2013a) Muzzin, A., Marchesini, D., Stefanon, M., Franx, M., et al. 2013a, ApJ, 777, 18
- Muzzin et al. (2013b) —. 2013b, ApJS, 206, 8
- Nguyen et al. (2010) Nguyen, H. T., Schulz, B., Levenson, L., Amblard, A., et al. 2010, A&A, 518, L5+
- Noeske et al. (2007) Noeske, K. G., Weiner, B. J., Faber, S. M., Papovich, C., et al. 2007, ApJ, 660, L43
- Oliver et al. (2010a) Oliver, S., Frost, M., Farrah, D., Gonzalez-Solares, E., et al. 2010a, MNRAS, 405, 2279
- Oliver et al. (2012) Oliver, S. J., Bock, J., Altieri, B., Amblard, A., et al. 2012, MNRAS, 424, 1614
- Oliver et al. (2010b) Oliver, S. J., Wang, L., Smith, A. J., Altieri, B., et al. 2010b, A&A, 518, L21+
- Ott (2010) Ott, S. 2010, in Astronomical Society of the Pacific Conference Series, Vol. 434, Astronomical Data Analysis Software and Systems XIX, 139–+
- Papovich et al. (2004) Papovich, C., Dole, H., Egami, E., Le Floc’h, E., et al. 2004, ApJS, 154, 70
- Pascale et al. (2008) Pascale, E., Ade, P. A. R., Bock, J. J., Chapin, E. L., et al. 2008, ApJ, 681, 400
- Pascale et al. (2009) —. 2009, ApJ, 707, 1740
- Peacock & Smith (2000) Peacock, J. A. & Smith, R. E. 2000, MNRAS, 318, 1144
- Penner et al. (2011) Penner, K., Pope, A., Chapin, E. L., Greve, T. R., et al. 2011, MNRAS, 410, 2749
- Pérez-González et al. (2008a) Pérez-González, P. G., Rieke, G. H., Villar, V., Barro, G., et al. 2008a, ApJ, 675, 234
- Pérez-González et al. (2008b) Pérez-González, P. G., Trujillo, I., Barro, G., Gallego, J., et al. 2008b, ApJ, 687, 50
- Piazzo (2013) Piazzo, L. 2013, ArXiv e-prints
- Piovan et al. (2003) Piovan, L., Tantalo, R., & Chiosi, C. 2003, A&A, 408, 559
- Planck Collaboration et al. (2013) Planck Collaboration, Ade, P. A. R., Aghanim, N., Armitage-Caplan, C., et al. 2013, ArXiv e-prints
- Planck Collaboration et al. (2011) Planck Collaboration, Ade, P. A. R., Aghanim, N., Arnaud, M., et al. 2011, A&A, 536, A18
- Poglitsch et al. (2010) Poglitsch, A., Waelkens, C., Geis, N., Feuchtgruber, H., et al. 2010, A&A, 518, L2
- Polletta et al. (2008) Polletta, M., Weedman, D., Hönig, S., Lonsdale, C. J., et al. 2008, ApJ, 675, 960
- Polletta et al. (2006) Polletta, M. d. C., Wilkes, B. J., Siana, B., Lonsdale, C. J., et al. 2006, ApJ, 642, 673
- Pope et al. (2008) Pope, A., Chary, R.-R., Alexander, D. M., Armus, L., et al. 2008, ApJ, 675, 1171
- Puget et al. (1996) Puget, J.-L., Abergel, A., Bernard, J.-P., Boulanger, F., et al. 1996, A&A, 308, L5+
- Quadri & Williams (2010) Quadri, R. F. & Williams, R. J. 2010, ApJ, 725, 794
- Quadri et al. (2012) Quadri, R. F., Williams, R. J., Franx, M., & Hildebrandt, H. 2012, ApJ, 744, 88
- Rawle et al. (2012) Rawle, T. D., Rex, M., Egami, E., Chung, S. M., et al. 2012, ApJ, 756, 106
- Richards et al. (2006) Richards, G. T., Lacy, M., Storrie-Lombardi, L. J., Hall, P. B., et al. 2006, ApJS, 166, 470
- Rieke et al. (2004) Rieke, G. H., Young, E. T., Engelbracht, C. W., Kelly, D. M., et al. 2004, ApJS, 154, 25
- Rodighiero et al. (2010) Rodighiero, G., Cimatti, A., Gruppioni, C., Popesso, P., et al. 2010, A&A, 518, L25
- Roehlly et al. (2011) Roehlly, Y., Buat, V., Heinis, S., Moreau, C., et al. 2011, in Astronomical Society of the Pacific Conference Series, Vol. 442, Astronomical Data Analysis Software and Systems XX, ed. I. N. Evans, A. Accomazzi, D. J. Mink, & A. H. Rots, 25
- Roseboom et al. (2012) Roseboom, I. G., Ivison, R. J., Greve, T. R., Amblard, A., et al. 2012, MNRAS, 419, 2758
- Roseboom et al. (2010) Roseboom, I. G., Oliver, S. J., Kunz, M., Altieri, B., et al. 2010, MNRAS, 409, 48
- Rowan-Robinson & Crawford (1989) Rowan-Robinson, M. & Crawford, J. 1989, MNRAS, 238, 523
- Salim et al. (2009) Salim, S., Dickinson, M., Michael Rich, R., Charlot, S., et al. 2009, ApJ, 700, 161
- Santini et al. (2010) Santini, P., Maiolino, R., Magnelli, B., Silva, L., et al. 2010, A&A, 518, L154
- Serjeant et al. (2010) Serjeant, S., Bertoldi, F., Blain, A. W., Clements, D. L., et al. 2010, A&A, 518, L7
- Serjeant et al. (2004) Serjeant, S., Mortier, A. M. J., Ivison, R. J., Egami, E., et al. 2004, ApJS, 154, 118
- Shang et al. (2012) Shang, C., Haiman, Z., Knox, L., & Oh, S. P. 2012, MNRAS, 421, 2832
- Skibba et al. (2011) Skibba, R. A., Engelbracht, C. W., Dale, D., Hinz, J., et al. 2011, ApJ, 738, 89
- Smail et al. (1997) Smail, I., Ivison, R. J., & Blain, A. W. 1997, ApJ, 490, L5+
- Smail et al. (2002) Smail, I., Ivison, R. J., Blain, A. W., & Kneib, J.-P. 2002, MNRAS, 331, 495
- Stansberry et al. (2007) Stansberry, J. A., Gordon, K. D., Bhattacharya, B., Engelbracht, C. W., et al. 2007, PASP, 119, 1038
- Stern et al. (2012) Stern, D., Assef, R. J., Benford, D. J., Blain, A., et al. 2012, ApJ, 753, 30
- Surace (2005) Surace, J. A. 2005, Technical Report, The SWIRE Data release 2
- Swinyard et al. (2010) Swinyard, B. M., Ade, P., Baluteau, J.-P., Aussel, H., et al. 2010, A&A, 518, L4
- Symeonidis et al. (2013) Symeonidis, M., Vaccari, M., Berta, S., Page, M. J., et al. 2013, MNRAS, 431, 2317
- Traficante et al. (2011) Traficante, A., Calzoletti, L., Veneziani, M., Ali, B., et al. 2011, MNRAS, 416, 2932
- Valiante et al. (2009) Valiante, E., Lutz, D., Sturm, E., Genzel, R., et al. 2009, ApJ, 701, 1814
- Viero et al. (2009) Viero, M. P., Ade, P. A. R., Bock, J. J., Chapin, E. L., et al. 2009, ApJ, 707, 1766
- Viero et al. (2013a) Viero, M. P., Asboth, V., Roseboom, I. G., Marsden, G., et al. 2013a, ArXiv e-prints
- Viero et al. (2012) Viero, M. P., Moncelsi, L., Mentuch, E., Buitrago, F., et al. 2012, MNRAS, 2405
- Viero et al. (2013b) Viero, M. P., Wang, L., Zemcov, M., Addison, G., et al. 2013b, ApJ, 772, 77
- Wang et al. (2013) Wang, L., Farrah, D., Oliver, S. J., Amblard, A., et al. 2013, MNRAS, 431, 648
- Warren et al. (2007) Warren, S. J., Hambly, N. C., Dye, S., Almaini, O., et al. 2007, MNRAS, 375, 213
- Weiß et al. (2009) Weiß, A., Kovács, A., Coppin, K., Greve, T. R., et al. 2009, ApJ, 707, 1201
- Wiebe et al. (2009) Wiebe, D. V., Ade, P. A. R., Bock, J. J., Chapin, E. L., et al. 2009, ApJ, 707, 1809
- Wieprecht et al. (2009) Wieprecht, E., Schreiber, J., de Jong, J., Jacobson, J., et al. 2009, in Astronomical Society of the Pacific Conference Series, Vol. 411, Astronomical Data Analysis Software and Systems XVIII, ed. D. A. Bohlender, D. Durand, & P. Dowler, 531
- Williams et al. (2009) Williams, R. J., Quadri, R. F., Franx, M., van Dokkum, P., et al. 2009, ApJ, 691, 1879
- Wilson et al. (2008) Wilson, G. W., Austermann, J. E., Perera, T. A., Scott, K. S., et al. 2008, MNRAS, 386, 807
- Wuyts et al. (2007) Wuyts, S., Labbé, I., Franx, M., Rudnick, G., et al. 2007, ApJ, 655, 51
Appendix A A. Tables
| – | |||||
|---|---|---|---|---|---|
| () | – | – | – | – | – |
| — | |||||
| – | |||||
| () | – | – | – | – | – |
| — | |||||
| — | |||||
| – | |||||
| () | – | – | – | – | – |
| — | |||||
| — | |||||
| — | |||||
| — | |||||
| — | |||||
| — | |||||
| – | |||||
| () | – | – | – | – | – |
| — | |||||
| — | — | ||||
| — | |||||
| — | |||||
| — | |||||
| — | |||||
| — | |||||
| – | |||||
| () | – | – | – | – | – |
| — | |||||
| — | — | ||||
| — | |||||
| — | — | ||||
| — | |||||
| — | |||||
| — | |||||
| — | |||||
| – | |||||
| () | – | – | – | – | – |
| — | |||||
| — | — | ||||
| — | |||||
| — | |||||
| — | |||||
| — | |||||
| — | |||||
| – | |||||
| () | – | – | – | – | – |
| — | — | ||||
| — | — | — | — | ||
| — | |||||
| — | — | ||||
| — | — | ||||
| — | |||||
| — | — | ||||
| – | |||||
| () | – | – | – | – | – |
| — | — | ||||
| — | — | ||||
| — | — | ||||
| — | |||||
| — | |||||
| – | |||
|---|---|---|---|
| () | – | – | – |
| — | |||
| — | |||
| — | |||
| — | — | ||
| — | — | — | |
| – | |||
| () | – | – | – |
| — | |||
| — | — | ||
| — | |||
| — | |||
| — | |||
| — | — | ||
| — | |||
| – | |||
| () | – | – | – |
| — | |||
| — | — | ||
| — | — | — | |
| — | |||
| — | |||
| — | |||
| — | |||
| — | — | — | |
| – | |||
| () | – | – | – |
| — | |||
| — | — | — | |
| — | — | ||
| — | — | ||
| — | — | ||
| — | — | ||
| – | |||
| () | – | – | – |
| — | |||
| — | |||
| — | — | ||
| — | — | ||
| – | |||
| () | – | – | – |
| — | |||
| — | — | ||
| — | |||
| — | |||
| — | |||
| — | |||
| — | |||
| — | |||
| – | |||
| () | – | – | – |
| — | |||
| — | — | ||
| — | |||
| — | |||
| – | |||
| () | – | – | – |
| — | |||
| — | — | ||
| — | — | ||
| — | |||
| — | |||
| — | |||
| — | |||
| — | |||
| Band | Type | – | – | – | – |
|---|---|---|---|---|---|
| () | () | () | () | () | |
| 24 | Stack | ||||
| CC | |||||
| SED | |||||
| 70 | Stack | ||||
| CC | |||||
| SED | |||||
| 100 | Stack | ||||
| CC | |||||
| SED | |||||
| 160 | Stack | ||||
| CC | |||||
| SED | |||||
| 250 | Stack | ||||
| CC | |||||
| SED | |||||
| 350 | Stack | ||||
| CC | |||||
| SED | |||||
| 500 | Stack | ||||
| CC | |||||
| SED | |||||
| 1100 | Stack | ||||
| CC | |||||
| SED |
| Band | Type | – | – | – | – | – |
|---|---|---|---|---|---|---|
| () | () | () | () | () | () | |
| 24 | Stack | |||||
| CC | ||||||
| SED | ||||||
| 70 | Stack | |||||
| CC | ||||||
| SED | ||||||
| 100 | Stack | |||||
| CC | ||||||
| SED | ||||||
| 160 | Stack | |||||
| CC | ||||||
| SED | ||||||
| 250 | Stack | |||||
| CC | ||||||
| SED | ||||||
| 350 | Stack | |||||
| CC | ||||||
| SED | ||||||
| 500 | Stack | |||||
| CC | ||||||
| SED | ||||||
| 1100 | Stack | |||||
| CC | ||||||
| SED |
| Band | Type | – | – | – |
|---|---|---|---|---|
| () | () | () | () | |
| 24 | Stack | |||
| CC | ||||
| SED | ||||
| 70 | Stack | |||
| CC | ||||
| SED | ||||
| 100 | Stack | |||
| CC | ||||
| SED | ||||
| 160 | Stack | |||
| CC | ||||
| SED | ||||
| 250 | Stack | |||
| CC | ||||
| SED | ||||
| 350 | Stack | |||
| CC | ||||
| SED | ||||
| 500 | Stack | |||
| CC | ||||
| SED | ||||
| 1100 | Stack | |||
| CC | ||||
| SED |